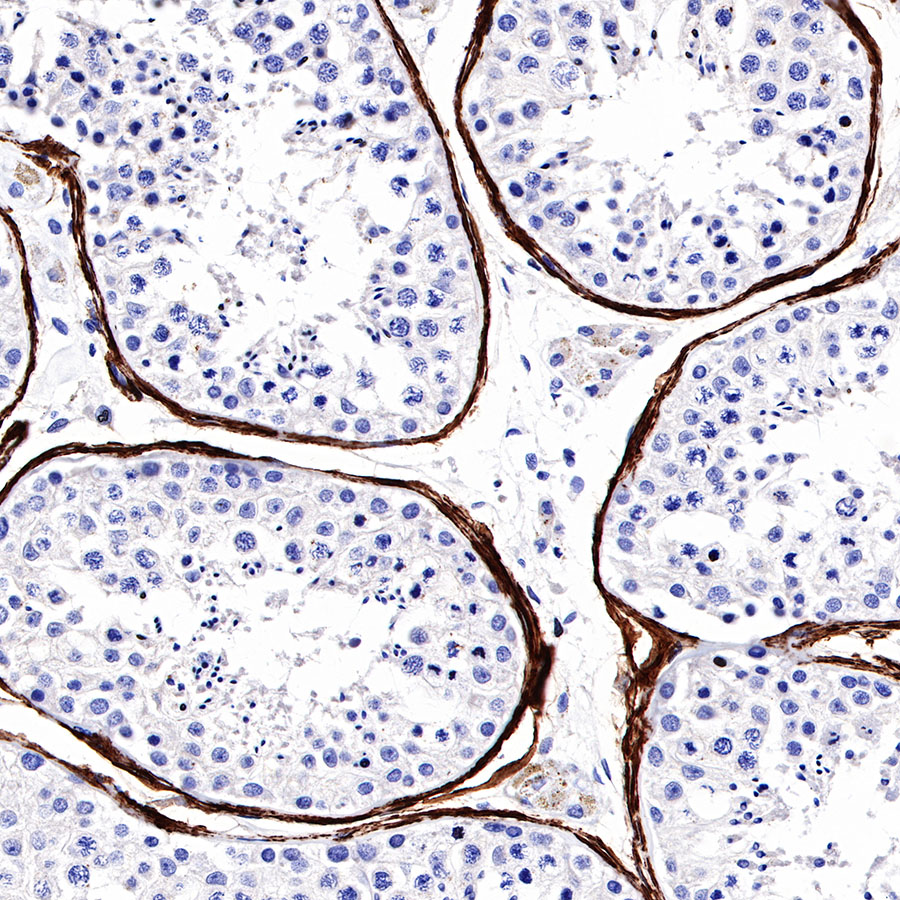
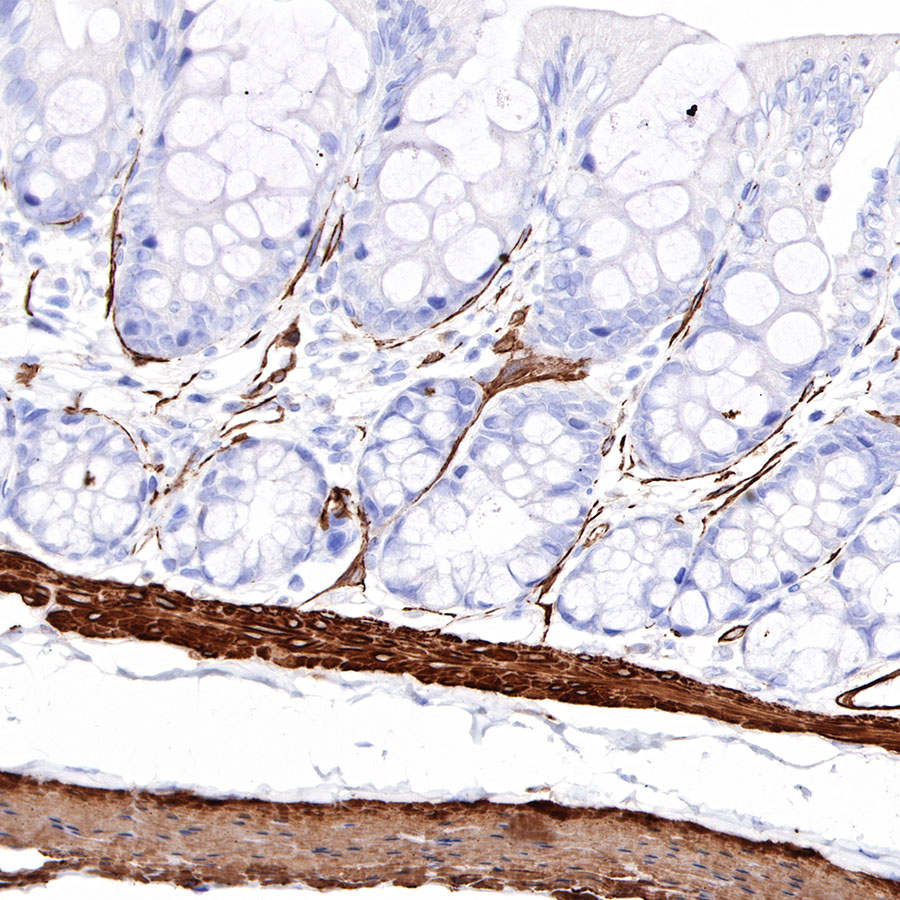
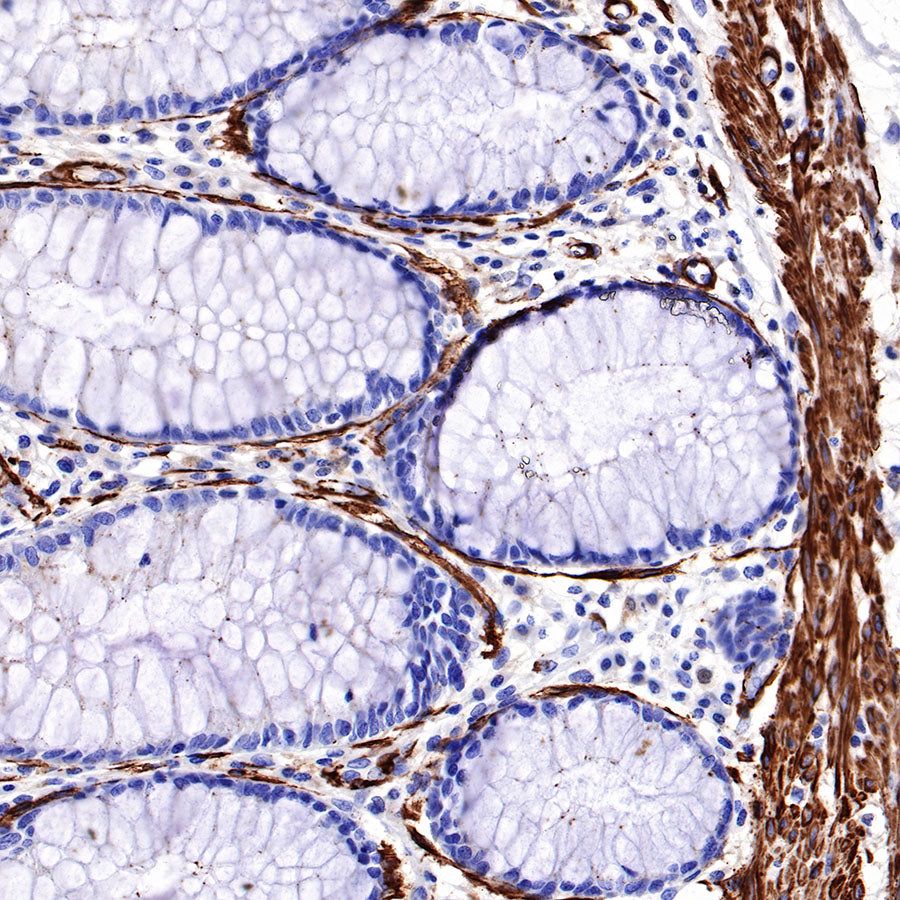

Product Details
Product Details
Product Specification
Host | Rabbit |
Antigen | alpha smooth muscle Actin (SMA) |
Synonyms | Alpha-actin-2, ACTA2, Smooth muscle actin, actin-sm, ASM-1, CGA7, ASM/H12 |
Immunogen | Synthetic Peptide |
Location | Cytoplasm, Cytoskeleton |
Accession | P62736 |
Clone Number | SDT-301-142 |
Application | WB, IHC-P, IF |
Reactivity | Hu, Ms, Rt |
Purification | Protein A |
Concentration | 0.25 mg/ml |
Physical Appearance | Liquid |
Storage Buffer | PBS, 40% Glycerol, 0.05% BSA, 0.03% Proclin 300 |
Stability & Storage | 12 months from date of receipt / reconstitution, -20 °C as supplied |
Dilution
application | dilution | species |
WB | 1:1000 | |
IHC-P | 1:1000 | |
IF | 1:500 |
Background
Alpha smooth muscle actin, encoded by ACTA2, is expressed in abundance in vascular smooth muscle, comprising 50–70% of total actin, with the remainder composed of β-cytoplasmic and γ-actins. Whereas α-smooth muscle expression is normally restricted to smooth muscle cells, it can also be expressed in non-muscle cells, most notably myofibroblasts that use cell traction forces to remodel extracellular matrix.
Picture
Picture
Western Blot

Immunohistochemistry

Immunofluorescence

IF shows positive staining in paraffin-embedded human colon. Anti- alpha smooth muscle Actin (SMA) antibody was used at 1/500 dilution (Green) and incubated overnight at 4°C. Goat polyclonal Antibody to Rabbit IgG - H&L (Alexa Fluor® 488) was used as secondary antibody at 1/1000 dilution. Counterstained with DAPI (Blue). Heat mediated antigen retrieval with EDTA buffer pH9.0 was performed before commencing with IF staining protocol.

IF shows positive staining in paraffin-embedded mouse colon. Anti- alpha smooth muscle Actin (SMA) antibody was used at 1/500 dilution (Green) and incubated overnight at 4°C. Goat polyclonal Antibody to Rabbit IgG - H&L (Alexa Fluor® 488) was used as secondary antibody at 1/1000 dilution. Counterstained with DAPI (Blue). Heat mediated antigen retrieval with EDTA buffer pH9.0 was performed before commencing with IF staining protocol.

IF shows positive staining in paraffin-embedded rat colon. Anti- alpha smooth muscle Actin (SMA) antibody was used at 1/500 dilution (Green) and incubated overnight at 4°C. Goat polyclonal Antibody to Rabbit IgG - H&L (Alexa Fluor® 488) was used as secondary antibody at 1/1000 dilution. Counterstained with DAPI (Blue). Heat mediated antigen retrieval with EDTA buffer pH9.0 was performed before commencing with IF staining protocol.